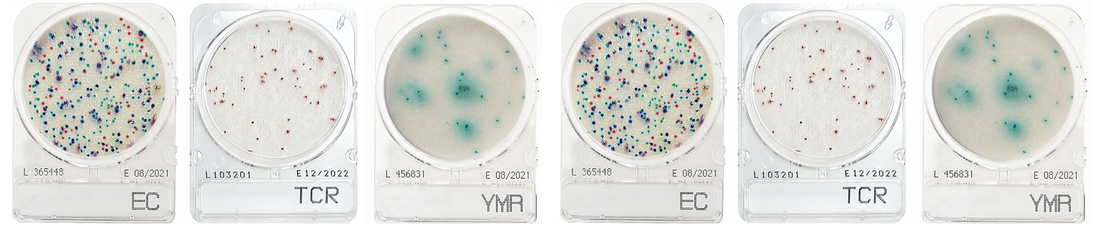
CompactDry range now live

Scientific and Technical Limited is delighted to announce our diagnostic CompactDry range is now live. These plates are ideal for manufacturers and researchers looking to determine contaminants in products and or surfaces. Suitable for bacterial, yeasts and moulds.
| Product | Target | Incubation temperature | Incubation time | Approval |
| CompactDry EC | E. coli and coliform | 37 ± 1 °C for all other matrices 35 ± 1 °C for raw meat | 24 ± 2 hours | AOAC/NordVal/MicroVal |
| CompactDry YMR | Yeast and Mould | 25 ± 1 °C | YMR: 72 ± 3 hours | AOAC/NordVal/MicroVal |
| CompactDry TCR | Total Viable Count | 35 ± 1 °C 32 ± 1 °C (dairy products) | 24 ± 2 hours 48 ± 3 hours | AOAC |